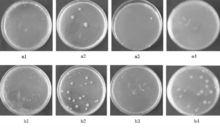

羅布麻纖維——野生纖維之王
羅布麻纖維素有“ 野生纖維之王”的美譽,早在三百年前,就被伊犁、若羌等地的勞動人民所用。他們織布成衣或者做被子、床單,說是可以祛病健身。羅布麻纖維的特性,比人們熟悉的蘭麻還要好,有絲的光澤,麻的挺括,棉的柔軟,絨的展性,並且有藥理作用,這是其它任何紡織原料都不能比擬的。近年來,天津百益爾康保健用品有限公司和東華大學、青島大學的有關學者對羅布麻纖維的服用功能做了很多深入地研究。
羅布麻纖維具有降壓、平喘、降血脂等作用
羅布麻含量為35% 以上的保健服飾具有降壓、平喘、降血脂等作用, 能明顯地改善臨床症狀。
羅布麻纖維的降壓原理主要有兩方面。一方面羅布麻纖維中的有效成分通過機體的皮膚滲透,作用於經絡、氣血、臟腑及局部病灶,起到調節血壓、降血脂、抗過敏、改善人體微循環的作用。另一方面羅布麻纖維是一種遠紅外線輻射材料,能發射出 8~15cm的遠紅外光波,這種光波使人體內老化的大分子團產生共振而裂化重組,使細胞內鈣離子活性增強,從而增強了細胞的活性,提高血液新陳代謝能力,達到降壓的效果;這種遠紅外光波還能切斷不飽和脂肪酸的二重鍵與三重鍵,減少血管內血脂數量,從而減少動脈硬化等疾病,增強人體免疫能力。
羅布麻纖維具有良好的抑菌性
羅布麻纖維具有良好的抑菌性, 對白色念珠菌、金黃色葡萄球菌、大腸桿菌、綠膿桿菌等有明顯的抑制作用, 對皮膚病、褥瘡、濕疹和婦科疾病有較好的防治作用, 同時對感冒、慢性支氣管炎等疾病也有一定的防治作用。
對此,青島大學紡織服裝學院的有關學者進行了嚴謹的實驗研究,並得出了客觀的數據,詳見下表和圖示結果。
致病菌 | 金黃色葡萄球菌 | 綠膿桿菌 | 大腸桿菌 | 白色念珠菌 |
羅布麻 | 47.7 | 69 | 56.6 | 40.1 |
棉 | -87.7 | -84.8 | 多不可計 | -29 |
由表中數據可以看出羅布麻纖維對革蘭染色菌類都有一定的抗菌抑菌性能,尤其是綠膿桿菌的作用能力比較強。
圖中:a1~ a4分別為羅布麻纖維對金黃色葡萄球菌、綠膿桿菌大腸桿菌、白色念珠菌作用後的結果;b1~ b4分別為棉纖維對金黃色葡萄球菌、綠膿桿菌、大腸桿菌、白色念珠菌作用後的結果。
羅布麻纖維發射的遠紅外線使其保暖性能優越
羅布麻纖維是天然的遠紅外發射材料,遠紅外線使得羅布麻內衣具有保暖作用,其保暖性在8℃以下是全棉內衣的2倍,21℃以上透氣性是純棉織物的2.5倍,獨具“冬暖夏爽”的特性。

日本築坡大學的名譽教授,醫學博士藤田化盛先生將純棉內衣和羅布麻內衣(麻35/棉65)作了試驗比較:穿著前測試體表溫度;穿著2種內衣15分鐘以維持體溫。純棉內衣脫掉後,5分鐘體表溫度下降到原溫度以下,而羅布麻內衣經15~20分鐘體表溫度仍能得到維持。
羅布麻纖維的橫截面是帶溝槽的橢圓形, 中間有一個橢圓形的孔, 使其具有吸汗、透氣的功能, 故是一種不可多得的天然纖維材料。
羅布麻纖維具有較強的抗紫外線輻射穿透性
羅布麻纖維具有較強的抗紫外線輻射穿透性,中國科學院上海技術物理研究所對羅布麻與棉纖維混紡內衣的測試:紫外線輻射的穿透率僅為2%。
天文醫學認為:人類的許多疾病都與太陽相關,過度的紫外線侵襲會導致反映遲鈍、早衰、皮膚癌等25種疾病。另據外電報導,北極上空的臭氧含量已減低到有史以來最低水平,致使太陽發出來的紫外線長驅直入,直射於人體。但是人們的普通衣著僅能阻隔30%~90%的紫外線,相比之下羅布麻織物卻有很好的禁止紫外線的能力。與棉纖維相比,羅布麻纖維大分子聚合度要高於棉纖維,從粗細程度上著,羅布麻纖維粗於棉纖維,所以進入纖維內部的輻射能量不同;另外,羅布麻纖維截面是不規則的腰圓形,有中腔,較小,纖維表面有許多豎紋,並有橫節存在,由於產生的反射、折射和透射程度引起的耐光性能也發生明顯的差異。
參考文獻
[1] 邢聲遠. 天然醫療保健纖維羅布麻 [J]. 北京紡織, 2001, 22( 2): 56 58.
[2] 盛言明. 保健降壓纖維羅布麻纖維商機無限[ EB /OL ]. [ 2006 03 18]. http: / /www. 1798. cn /Q ybl/newshow. asp? new sid= 512& id= 17356.
[3] 呂銳, 蘇冬梅. 羅布麻纖維的抗菌性能研究 [J]. 青島大學醫學院學報, 2006, 42(1): 72.
[4] 鄭麗莎高山王侖喬鐵軍孫寶芬.羅布麻纖維抗菌機理研究[J] .檢驗檢疫學刊, 2009,(3): 13~ 16
[5] 鄭麗莎.羅布麻纖維抗菌性能及機理研究[J] . 青島大學紡織服裝學院學報,2004,5
[6] 新潮實業.羅布麻保健內衣,服裝科技,1999(6):62~63
[7] 宋向陽,孫德明.羅布麻資源開發
羅布麻
是野生植物纖維。由於最初在新疆羅布泊發現,故命名為羅布麻。羅布麻有紅麻和白麻之分,前者植株高大,幼苗為紅色,莖高達1.5~2 m,最高可達4m以上;後者植株較矮小,幼苗為淺綠色,莖高為1~1.5m,最高可達2.5 m.由於它喜光﹑耐旱﹑耐鹼﹑耐寒﹑適應性強,適宜於在鹽鹼﹑沙漠等惡劣的自然條件下生長,因此廣泛分布在淮河﹑秦嶺﹑崑崙山以北地區的十幾個省﹑市﹑自治區,主要集中在新疆﹑內蒙古﹑甘肅和青海等地。在山東的黃河口﹑陝西﹑江蘇等地也有發現,因屬野生植物纖維,枯死後莖桿都呈紅色,故又名紅野麻。據不完全統計,我國生長羅布麻的土地約有133萬公頃,產量可達10萬噸,其中,新疆約有53萬公頃,產量 約為5萬噸。
布麻是一種具有優良品質的麻纖維。除了具有一般麻類纖維的吸濕﹑透氣﹑透濕性好﹑強力高等共同特性外,還具有絲一般的良好的手感,纖維細長,耐濕抗腐,可供紡織之用,其產品具有一定的醫療保健作用,高血壓患者穿著有顯著的降壓效果。在中醫上常採用羅布麻地上部分入藥,其性微寒﹑味甘苦,有清熱降火﹑平肝熄風功能,主治頭痛眩暈﹑失眠等 症。葉含羅布麻苷,葉還可以作飲料或飼料,莖﹑葉所含乳膠液可提煉橡膠,故羅布麻具有很高的經濟價值和醫療價值,深受人們的重視與青睞。
布麻是一種韌皮纖維,它位於羅布麻植物莖桿上的韌皮組織內,纖維細長而有光澤,呈非常鬆散的纖維束,個別纖維單獨存在。羅布麻單纖維是一種兩端封閉﹑中間有胞腔﹑中部粗而兩端細的細胞狀物體,截面呈明顯不規則的腰子形,中腔較小,纖維縱向無扭轉,表面有許多豎紋並有橫節存在。纖維細度約為0.3~0.4tex ,長度與棉纖維相近,平均長度為20~25mm ,但長度差異較大,其幅度為10~40mm ,寬度約為10~20mm ,纖維潔白,質地優良。但由於表面光滑無捲曲,抱合力小,在紡織加工中容易散落,製成率低,且影響成紗質量。羅布麻是麻類纖維中品質僅次於苧麻的優良纖維,若以單纖維與棉纖維或化學纖維混紡,效果較好。
羅布麻經過剝麻﹑晾曬等初步加工後成為原麻,原麻中較多的膠質,必須進行脫膠處理 。由於羅布麻單纖維的長度較長,給脫膠帶來一定的困難,故常採用化學脫膠工藝進行全脫膠,這樣可除去纖維中的絕大部分膠質,以提高纖維的紡紗性能。化學脫膠的工藝流程如下:
(原麻)分棟→浸酸→水洗→一煮→二煮→水洗→打纖→漂白→酸洗→水洗→給油→脫水→烘乾(精幹麻)。
化學脫膠後的精幹麻,仍含有少量的(一般只有百分之幾)殘膠,其中還包括一定數量的果膠﹑半纖維素和木質素等,因此在紡紗之前還要對精幹麻進行給油加濕等預處理,以提高其可紡性能。
布麻的化學組成與其它麻類纖維有一定的區別。羅布麻的果膠含量13.14%﹑水溶物含量17.22%,居麻類各纖維之冠,木質素含量12.14%高於苧麻﹑亞麻﹑大麻﹑蕉麻和劍麻,而纖維素含量40.82%是所有麻類纖維中最低的。但也有資料報導約為62%~72%,與亞麻纖維的含量相當。羅布麻纖維的化學組成決定了它的理化性能,根據羅布麻纖維射線衍射與紅外光譜分析結果,羅布麻纖維的內部結構與棉﹑苧麻極為相似,內部分子結構緊密,在結晶區中纖維大分子排列較為整齊,結晶度與取向度均較高。
布麻是我國近年來新開發的天然纖維,既具有麻類纖維的一些共同性質,又具有自身的一些特點,不僅具有優良的服用性能,而且還具有良好的醫療保健功能,特別適宜於製做夏季的服裝,是名不虛傳 的"神衣"。